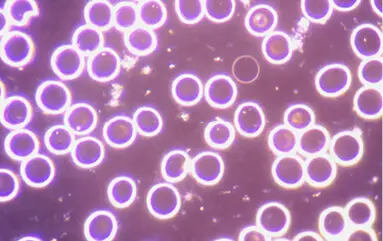
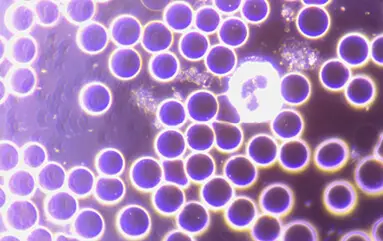

memon
Technologie
Le principe de fonctionnement de la technologie memon

Comment cela fonctionne
suppression du bruit
La technologie memon fonctionne de manière similaire à la suppression du bruit dans un cockpit. Pour neutraliser le son, on génère un contre-son (une source de contre-information) qui correspond à celui du son perturbateur.
Avec memon, toutes les ondes d'information nuisibles sont neutralisées par le circuit électrique des pièces, mais les ondes techniques demeurent, de sorte que toute la technologie peut continuer à être utilisée sans restriction.
Lors de mesures des ions dans l'air et des poussières fines effectuées par la société Grimm Aerosol GmbH en 2020 dans la brasserie Stiegl à Salzbourg, il a été possible de constater que l'utilisation de la technologie memon a permis de réduire jusqu'à 80% les poussières fines dans l'air respiré à l'intérieur.